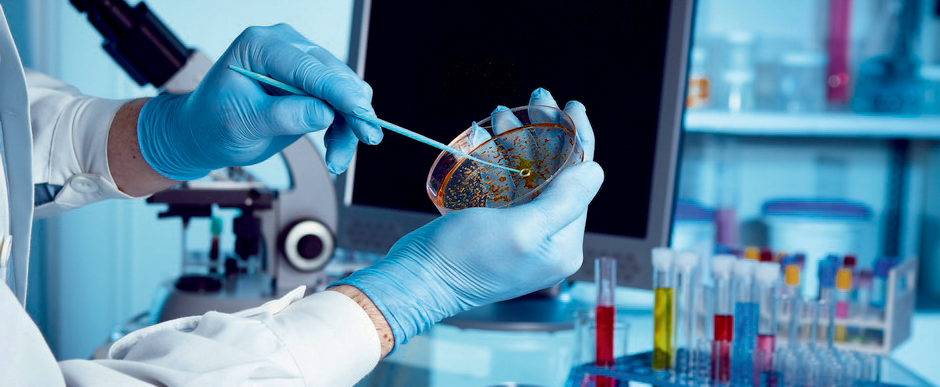
interpretazione risultati iso microbiologico

Armonizzazione nella normazione (ISO) per l’ambito microbiologico
Da tempo immemore, le organizzazioni umane, che siano esse tribù o imperi, spendono energie e risorse allo scopo fondamentale di normare e di conseguenza armonizzare le prestabilite regole con il fine ultimo di rinsaldare i propri rapporti di natura sociale, medica, militare o commerciale. In particolar modo, dopo il termine dell’ultimo conflitto mondiale e il successivo esteso periodo di pace tra le nazioni europee, si è andata a rafforzare la consapevolezza che in un blocco occidentale strettamente interconnesso fosse necessario parlare la stessa lingua, per lo meno in prima battuta nei settori tecnico e commerciale. Ragion per cui, in sede di promulgazione di nuove leggi nella nostra epoca, non è più possibile prescindere da una normazione tecnica che passi da una standardizzazione, al fine di stabilire parametri, metodiche, raccolta e interpretazione dati, anche e soprattutto nel complesso emisfero microbiologico.
Settore pubblico
Il punto di riferimento per ogni cittadino che intenda avere un primo approccio con l’argomento è senza alcun dubbio l’attuale corpus normativo. In particolar modo, per i cittadini italiani ed europei è fondamentale riferirsi alle leggi promulgate dallo Stato italiano dall’Unione Europea. Entrambi gli apparati pubblici provvedono ad elencare regolamenti e direttive (nel caso della UE, dove il regolamento va inteso come una legge immediatamente applicabile, a differenza della direttiva che obbliga gli Stati a legiferare in una certa direzione) oppure leggi, decreti legge e decreti legislativi (nel caso dello Stato italiano).
Volendo immaginare la situazione in cui si necessita di sottoporre un campione ad analisi microbiologiche dalla valenza ufficiale, in Italia bisogna rivolgersi ai laboratori accreditati da Accredia: in applicazione del Reg. europeo 765/08, il Ministero dello Sviluppo Economico italiano ha designato questo ente senza scopo di lucro come unico, indipendente e imparziale a poter certificare, verificare e ispezionare i laboratori di prova e taratura. Quindi, Accredia è l’unico ente sul suolo italiano che può conferire validità ufficiale a quei laboratori microbiologici che vogliano effettuare analisi dalla valenza ufficiale (ad esempio, in caso di perizie demandate dalla Pubblica Amministrazione).
I laboratori che eseguono analisi ufficiali, ma anche ad esempio in caso di laboratori di controllo interno in aziende manifatturiere che vogliano adeguarsi a determinati standard, seguono a loro volta direttive e regolamenti nazionali e comunitari che stabiliscono criteri univoci applicabili ai diversi settori. A titolo esemplificativo, nel settore alimentare il Reg. europeo 2073/05 stabilisce i criteri microbiologici applicabili ai prodotti alimentari; il Decreto Legislativo 116/2008 fissa invece i parametri microbiologici utili per la suddivisione delle acque di balneazione in zone qualitativamente diverse. Ancora, il Decreto Legislativo 152/2006, il cosiddetto Testo Unico ambientale (che costituisce un vero e proprio manuale legislativo al servizio del cittadino, delle imprese e di ogni categoria), stabilisce ad esempio i parametri microbiologici e le modalità di campionamento, trasporto e conservazione di acque reflue da sottoporre ad analisi microbiologiche.
Settore privato
Avendo reso chiaro il concetto di ufficialità di una prova e/o di un risultato di analisi, va da sé che i laboratori che conducono un determinato tipo di prova si adeguano a precise metodiche universalmente accettate e riconosciute come valide in quanto collaudate, istituite e ampiamente applicate in molteplici contesti.
In Italia, la normazione tecnica è affidata all’UNI – Ente Nazionale Italiano di Unificazione, ovvero un’associazione privata senza scopo di lucro, i cui soci, oltre 7000, sono imprese, liberi professionisti, associazioni, istituti scientifici e scolastici e persino realtà della Pubblica Amministrazione. L’UNI svolge attività normativa in tutti i settori industriali, commerciali e del terziario ad esclusione di quello elettrico ed elettrotecnico (competenza esclusiva del Comitato Elettrotecnico Italiano). Il ruolo dell’UNI, quale Organismo nazionale italiano di normazione, è stato riconosciuto dalla Direttiva Europea 83/189/CEE del 1983 e recepita dal Governo Italiano con la Legge n. 317/86.
In rappresentanza dell’Italia, l’UNI partecipa alle attività di normazione del Comitato Europeo di Normazione (CEN, indicato spesso con la sigla EN davanti al codice numerico delle norme tecniche) e del più celebre e diffuso organismo internazionale di normazione, vale a dire ISO.
Contrariamente a quanto si può pensare, ISO non è acronimo di International Standard Organization, bensì sta ad indicare l’uguaglianza in quanto armonizzazione, poiché riprende la parola greca ἴσος (isos, uguale). Si tratta della più importante organizzazione internazionale di promulgazione di regole tecniche, ha sede a Ginevra ed è riconosciuta in 165 Stati. Nel corso della sua decennale attività, ISO ha pubblicato più di 22000 standard riguardanti una vasta gamma di attività: dalla produzione di un prodotto alla gestione di un processo lavorativo, passando per le analisi svolte su di esso (tra cui, appunto, quelle microbiologiche) fino alla fornitura di un materiale o di un servizio. Questo aspetto è molto importante poiché, nello scenario attuale di globalizzazione, la competitività di un’impresa sui mercati si misura anche e soprattutto dall’aderenza della stessa a tali norme, che vanno a costituire quindi un’attestato di affidabilità e rigore nella conduzione dei lavori.
Microbiologia e norme ISO
I parametri microbiologici, le metodiche di analisi, i terreni di coltura e le condizioni di incubazione in fase di analisi di campioni ambientali, alimentari, medici, cosmetici e tanto altro, sono oggi strettamente legati a quelli che sono gli standard promulgati dalla ISO. Soffermandoci su alcune norme, è possibile comprendere come la capillarità e l’estrema precisione della standardizzazione abbia reso più semplice e al contempo efficace la conduzione delle analisi microbiologiche che oggi vengono svolte con grande frequenza.

Prendendo come esempio la norma ISO 18593:2004 “Microbiology of food and animal feeding stuffs. Horizontal method for sampling techniques from surfaces using contact plates and swabs” è facile rendersi conto di come questa sia applicabile non solo all’ambito della lavorazione di prodotti destinati all’alimentazione, ma fornisce indicazioni relative al campionamento e all’analisi che possono essere quindi utili anche per l’analisi di superfici presenti in altri ambienti lavorativi.
Facendo riferimento invece alla norma ISO 14644-1 e 2:2015 “Camere bianche ed ambienti associati controllati – Classificazione della pulizia dell’aria”, essa definisce le classi di pulizia (ISO 1, ISO 2 ecc.) e i livelli di contenuto particellare massimo previsti e applicabili in ogni ambiente controllato, rimandando anche a “i livelli di pulizia delle superfici delle camere bianche e ambienti associati, individuando criteri di classificazione basati sulla concentrazione delle particelle” fornendo “indicazioni circa la presenza di diversi metodi e procedure per determinare la concentrazione delle particelle su superfici”.
Nell’elencazione delle molteplici norme, non di certo riassumibile in poche righe, ci si rende conto di come l’Organizzazione abbia provveduto a dettagliare ogni aspetto che possa quindi essere incluso in un più ampio contesto di armonizzazione che punti ad ottenere risultati simili tra prove diverse svolte in laboratori diversi da personale eterogeneo.
Considerazioni a margine
Qualunque regolamento, direttiva, legge, norma o standard nasce da un’esigenza: senza dubbio, tenere quanto più basso possibile il margine di errore è l’obiettivo di tutti i tecnici, analisti o ricercatori, ma talvolta ciò non è sufficiente a rendere riproducibile un risultato. Essendo la microbiologia una branca della biologia, quindi una disciplina scientifica a tutti gli effetti che richiede metodo e rigore analitico, è necessario prendere atto di una caratteristica che la contraddistingue da altre importanti e altrettanto valide materie: la dispersione assolutamente casuale dei microrganismi, che può quindi essere letta come un fattore di imponderabilità, pone il microbiologo dinanzi ad una constatazione e cioè che i risultati, molto spesso, per avere una validità che sia davvero considerevole, debbono essere comparativi. Ciò non esclude, semmai fortifica, il concetto di precisione e attendibilità dei responsi. A supporto di ciò, l’adozione di standard e metodiche comuni non può che costituire una limitazione all’imprecisione e alla variabilità dei risultati; se due, tre o dieci laboratori possono presentare due, tre o dieci risultati diversi, ciò è comunque mitigato dal fatto che i due, i tre o i dieci laboratori adotteranno un principio, una linea guida comune che li avvicinerà in senso probabilistico a ciò che corrisponde a verità.
Fonti
- Decreto Legislativo 116/2008
- Decreto Legislativo 152/2006
- Reg. UE 765/08
- Reg. UE 2073/05
- Le norme tecniche per il controllo microbiologico delle superfici – ESHQ Consulting Srl – ESHQ Consulting Srl
- ISO – International Organization for Standardization